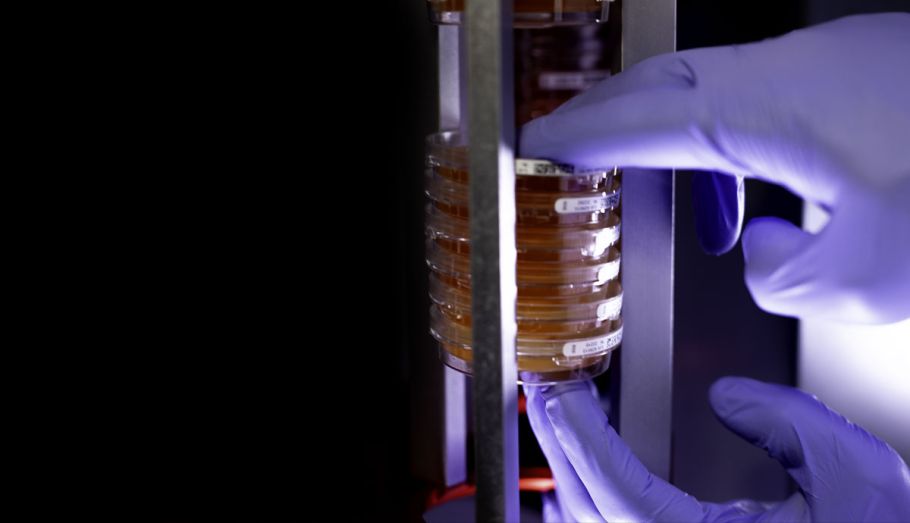

bacSpot ML
Colony Counter
Der AID bacSpot ML ist die automatische Lösung um Kolonien zu zählen bei geringem Plattenaufkommen. Mit Hilfe technisch ausgereifter Beleuchtung und Software stellt der AID bacSpotML praktisches und zuverlässiges Zählen und die korrekte Dokumentation der Ergebnisse sicher.
Durch die vielfältigen Möglichkeiten der Software, steht der AID bacSpotML dem Robotic System in Hinblick auf Analyse und Datenintegration in LIMS-Systeme in nichts nach.
Prozessierung verschiedener Plattentypen
60 mm und 90 mm Platten aller Hersteller

Präzises Auszählen verschiedener KbE
Anpassbar auf viele verschiedene Kolonien bildende Mikororganismen

Einfache Einbindung in jeden Arbeitsablauf
integrierter Barcode Scanner und Anbindung an viele verschiedene QC und LIMS Systeme möglich

bacSpot ML System
Plattenflexibilität und Analysenstärke
Mit dem bacSpot ML geben wir dem Kunden einen Colony Counter für die Auswertung von Einzelplatten an die Hand, der zunächst als Technologie-erprobungsträger für den bacSpot Robot konstruiert wurde. Das Gerät wird mit einer für den bacSpot ML angepassten, aber zu den bacSpot Robots äquivalenten Software bedient, die den Auswertemöglichkeiten der Hochdurchsatzgeräte in nichts nachsteht. Der bacSpot ML ist für diverse Plattenformate geeignet.
Kolonien im Scheinwerferlicht
Flexible Beleuchtung und Koloniedarstellung
Eine der grundlegenden Stärken der bacSpot Systeme sind die ausgeklügelten Beleuchtungseinheiten für die Bildaufnahme und die nachfolgende Bildverarbeitung. Der bacSpot ML bietet mit seinen Auflicht-, Durchlicht- und Dunkelfeld-Optionen, ein optimales Analysenwerkezug für sehr schwer darstellbare Kolonien. Die Beleuchtungsvorrichtungen können in Höhe und Winkel über dem Objekt frei eingestellt werden.

